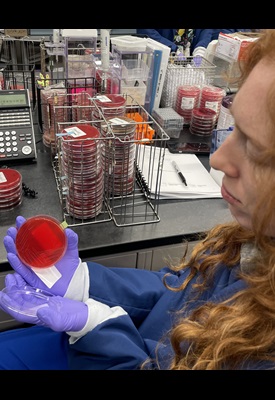
Medical Laboratory Science

Course Descriptions
The major courses (Clinical Chemistry, Clinical Immunohematology, Clinical Microbiology, and Hematology) incorporate an in-depth didactic section, a student laboratory where the student learns skills needed to manually perform test methodologies, and a clinical rotation experience which validates the cognitive learning portion and introduces technological advances. In both the student and clinical laboratory, the student learns of laboratory safety procedures, assesses specimen quality, manages pre-analytical issues, identifies critical values and post-analytical situations. The Laboratory Information System and other functionalities are utilized throughout.

Clinical Immunohematology/Blood Banking/ Transfusion Medicine
DIDACTIC PORTION: the core topics include: principles and practices of various blood systems (ABO, Rh), blood banking reagents; principles of whole blood donation, donor selection, and donor blood testing, autologous donors, cellular components preparation, storage, blood group serology, safety, and quality assurance in blood banking, blood group systems and their significance, pre-transfusion testing, detection and identification of significant antibodies, investigation of suspected adverse transfusion reaction, compatibility of recipient and donor testing, and resolution of incompatible cross-matches.STUDENT LABORATORY: this section teaches the student serological techniques in blood group serology, preparation of cells, various grades of reactions, problems in blood typing, and the performance of many critical specialized test methods.
CLINICAL ROTATION: this area includes bench procedures where the student will validate his/her learning skills and the application of technological advances as applied in Blood Bank. The student will survey a specimen to illustrate the workflow of requests for blood transfusion, including blood typing, cross-matching, and other testing, and final selection of donor blood.

Clinical Microbiology
DIDACTIC PORTION: the core curriculum design for Clinical Microbiology emphasizes the study of medically significant microorganisms. It is subdivided into bacteriology, mycology, virology, mycobacteriology and parasitology. Infectious diseases are reviewed by organ system. Lectures focus on physiology, life cycles, transmission, symptomology and treatment of disease and laboratory identification.MOLECULAR DIAGNOSTICS: this sub-section covers the fundamentals of molecular biology, nucleic acid biochemistry, genetics, and its molecular testing applications, mutations and polymorphisms. The lecture portion includes structure and function of DNA, DNA replication, genetics, molecular methodologies, restriction enzymes and specific types of electrophoresis.
STUDENT LABORATORY: the student becomes proficient in basic microbiological skills and techniques through isolation and identification of clinically significant microbes. Biochemical reactions, special stains, microscopy and serological screening procedures are utilized. In addition, ova and parasites are identified from trichrome and wet prep slides.
CLINICAL ROTATION: this experience gives the student an in-depth base of isolating and identifying pathogens and commensal flora. This is followed by determining the appropriate antimicrobial susceptibility testing. In Molecular Diagnostics, he /she will learn the newest techniques along with DNA based assays such as PCR and methods to detect DNA and RNA.


Clinical Chemistry
DIDACTIC PORTION: this phase covers such topics as carbohydrates, proteins, lipids, hormones, electrolytes with acid–base relationships and blood gas studies, liver function tests, non-protein nitrogen compounds, tumor markers, enzymes and reactions, and genetic disorders. Additional lectures are also provided in vitamins and pro-vitamins, trace metals, pharmacokinetics, therapeutic drug monitoring, toxicology, and immunofluorescence electrophoresis interpretation. The student learns principles of complex laboratory technology and methodologies through lectures and videos in the Instrumentation component. Classroom concepts are reinforced by homework assignments and problem exercises.STUDENT LABORATORY: this experience teaches the student analytical procedures using statistics and standard graphs. He/she will master psychomotor skills, pipetting techniques and applications of manual spectrophotometric assays.
CLINICAL LABORATORY: this area affords the student an opportunity to operate, troubleshoot and perform quality control procedures on state-of-the-art instrumentation. These analyzers incorporate various methodologies for the determination of clinically significant compounds. By utilizing these, he/she gains proficiency in accurate test resulting and interpretation.


Hematology
DIDACTIC PORTION: the core topics include hematopoiesis, granulopoiesis, erythropoiesis, megakaryopoiesis, lymphopoiesis, routine and advanced hematological methodologies and instrumentation (e.g. flow cytometry). The course provides a comprehensive study of anemias with a thorough background of morphological and cellular characteristics associated with the various types of anemias, acute leukemias, myeloproliferative disorders, lymphoproliferative disorders and other blood cell disorders. The student learns the application of cytochemical stains while studying leukemia, simultaneously grasping concepts of cytogenetics, molecular diagnosis, and flow cytometry. The student is challenged with case studies to foster an environment of critical thinking to link test results with associated conditions, diagnosis, treatment, and prognosis. A subdivision of Hematology is Coagulation, a study of the complex interactions of the vascular system, platelets, and coagulation factors which maintain the integrity of blood in a fluid state. The student will learn the importance of the formation of a platelet plug to stop minor bleeding and finishing up with the fibrinolytic system.STUDENT LABORATORY: the Hematology experience teaches the student psychomotor skills and hematological techniques such as; use and care of microscopes, peripheral blood slide making, staining of cells, and the identification of cellular components (both immature and mature forms). The student is taught to run supplemental test procedures such as: sickle cell screening, erythrocyte sedimentation rates, manual cell counting, manual reticulocyte counts and differential cell counts with morphological grading. The Coagulation phase begins with hands-on manual testing involving clotting procedures and proceeds to utilizing some automation.
CLINICAL LABORATORY: this area provides the student a diverse opportunity for practical skills to operate state-of-the art analyzers for complete blood count (CBC), Cellavision technology, body fluid counts, cytocentrifuge smear making, troubleshooting, result interpretation and much more.
Urinalysis and Body Fluids
This course encompasses the study of urine and other body fluids. The Urinalysis section includes the overview of the anatomy and physiology of the kidneys using urine as a component to diagnose disease and monitor disease progression therapy. This area also focuses on types of specimen collection, storage and preservation of specimens, testing procedures, microscopy, and instrumentation. Body fluids continues with the analysis of the many various types of fluids such as; cerebral spinal, synovial, serous, seminal, amniotic, vaginal, and fecal. Details include fluid formation, volumes for testing, testing procedures, cell counting, and correlation and monitoring of disease by means of fluid analysis.STUDENT LABORATORY: the Urinalysis section offers the student an opportunity to explore the three main areas of testing: macroscopic, biochemical, and microscopic analysis. Body fluids determinations are done manually through cell counts using the hemocytometer, followed by differential cell counts using a cytospin slide.
CLINICAL LABORATORY: the Urinalysis area adds the operation of innovative urine analyzers to the three parts of urinalysis testing. Analyses, recording and reporting on various types of body fluids such as peritoneal, pleural, seminal, synovial and cerebral are performed during the Hematology Rotation.
Immunology
Many of the immunological tests have been re-distributed in various areas of the medical laboratory; for example, agglutination reactions may be seen in the Blood Bank department and immunoassays may be seen in Microbiology and Clinical Chemistry. This course begins with lectures in immunity; antigens and antibodies, cells and cellular activities of the immune system (granulocytes, monocytes, lymphocytes, plasma cells), and the role of complement. The next group of lectures entails basic serological techniques and the principles of testing. Further in the course are immunoassays and various labeling techniques, molecular techniques, radioimmunoassay (RIA), Ouchterlony, and electrophoresis. In addition, this course includes infectious diseases and immunological responses with testing for autoimmune disorders, immunodeficiency, tumor associated antigens, and complement disorders.Laboratory Management, Education, and Research
LABORATORY MANAGEMENT: these lectures include current health care Reform parameters, Federal regulations and national organizations, general management theories, critical thinking, financial management, computers in the laboratory and laboratory information systems (LIS), personnel management, and team building. The student will construct his/her resume in preparation for application to laboratory positions as a medical laboratory scientist.
CLINICAL EDUCATION: this module consists of exploring the characteristics of effective clinical instructors, tips in writing behavioral objectives and goals, the three domains of learning, teaching methods, testing, and evaluation.
RESEARCH: this module gives the student an opportunity to witness a Hackensack Meridian Health Research Day and to prepare a student clinical case study project.

